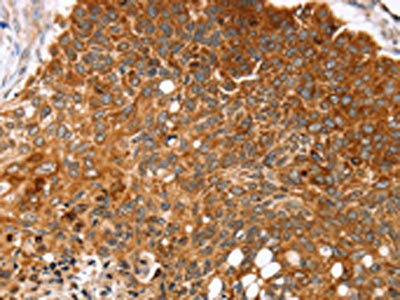

MGST1 Antibody
-
中文名稱:MGST1兔多克隆抗體
-
貨號:CSB-PA218758
-
規(guī)格:¥1100
-
圖片:
-
The image on the left is immunohistochemistry of paraffin-embedded Human esophagus cancer tissue using CSB-PA218758(MGST1 Antibody) at dilution 1/35, on the right is treated with synthetic peptide. (Original magnification: ×200)
-
The image on the left is immunohistochemistry of paraffin-embedded Human brain tissue using CSB-PA218758(MGST1 Antibody) at dilution 1/35, on the right is treated with synthetic peptide. (Original magnification: ×200)
-
-
其他:
產(chǎn)品詳情
-
Uniprot No.:
-
基因名:MGST1
-
別名:MGST1; GST12; MGST; Microsomal glutathione S-transferase 1; Microsomal GST-1; Microsomal GST-I
-
宿主:Rabbit
-
反應種屬:Human
-
免疫原:Synthetic peptide of Human MGST1
-
免疫原種屬:Homo sapiens (Human)
-
標記方式:Non-conjugated
-
抗體亞型:IgG
-
純化方式:Antigen affinity purification
-
濃度:It differs from different batches. Please contact us to confirm it.
-
保存緩沖液:-20°C, pH7.4 PBS, 0.05% NaN3, 40% Glycerol
-
產(chǎn)品提供形式:Liquid
-
應用范圍:ELISA,IHC
-
推薦稀釋比:
Application Recommended Dilution ELISA 1:2000-1:5000 IHC 1:25-1:100 -
Protocols:
-
儲存條件:Upon receipt, store at -20°C or -80°C. Avoid repeated freeze.
-
貨期:Basically, we can dispatch the products out in 1-3 working days after receiving your orders. Delivery time maybe differs from different purchasing way or location, please kindly consult your local distributors for specific delivery time.
-
用途:For Research Use Only. Not for use in diagnostic or therapeutic procedures.
相關產(chǎn)品
靶點詳情
-
功能:Conjugation of reduced glutathione to a wide number of exogenous and endogenous hydrophobic electrophiles. Has a wide substrate specificity.
-
基因功能參考文獻:
- High MGST1 expression is associated with Bendamustine-resistance in Mantle Cell Lymphoma. PMID: 29695404
- Significant association for germline variations only in the COX pathway (specifically in the antioxidant microsomal glutathione S-transferase 1 [MGST1] gene), with risk for Barrett's esophagus and the combined outcome of Barrett's esophagus and esophageal adenocarcinoma was found. PMID: 29713984
- This study provides the most comprehensive evaluation of inflammation-related germline variation in relation to risk of BE/OA and suggests that variants in MGST1 influence disease susceptibility. PMID: 27486097
- The MSGT1 displays a preexisting dynamic equilibrium between high- and low-activity forms. PMID: 28558199
- possibly marked variations in NB mitochondrial homeostasis, they also imply that the results of these earlier studies using NB cells are not transferable to other tumor and cell types that express MGST1 at high concentrations. PMID: 24486338
- Differential expression of SOD2, ALDH1A1, and MGST1 genes in the anterior lens capsules of patients with pseudoexfoliation syndrome suggest that diseased tissue appears to respond to the previously reported oxidative stress. PMID: 23805041
- The results suggest that MGST1 gene polymorphisms as one of environment gene may contribute to colorectal cancer risk in younger ages. PMID: 23314968
- MGST1 protects cells (and mitochondria) by both conjugation and glutathione peroxidase functions. A new protective mechanism against cisplatin is also indicated PMID: 20727966
- Polymorphisms in microsomal glutathione s transferase is associated with laryngeal cancer PMID: 12359356
- The results indicate that Sp1 is the protein mediating the basal transcription of MGST1 PMID: 12818425
- Genes encoding KU70, MGST1 and BIK show age-related mRNA expression levels in hematopoietic stem cells. PMID: 17714764
- As an addition to the high-density SNP (single-nucleotide polymorphism) maps of 12 glutathione S-transferase and related genes reported earlier, a SNP map of the microsomal glutathione S-transferase 1 (MGST1) gene is provided. PMID: 11587073
顯示更多
收起更多
-
亞細胞定位:Microsome. Mitochondrion outer membrane; Peripheral membrane protein. Endoplasmic reticulum membrane; Multi-pass membrane protein.
-
蛋白家族:MAPEG family
-
組織特異性:Highly expressed in liver.
-
數(shù)據(jù)庫鏈接:
Most popular with customers
-
-
YWHAB Recombinant Monoclonal Antibody
Applications: ELISA, WB, IHC, IF, FC
Species Reactivity: Human, Mouse, Rat
-
Phospho-YAP1 (S127) Recombinant Monoclonal Antibody
Applications: ELISA, WB, IHC
Species Reactivity: Human
-
-
-
-
-